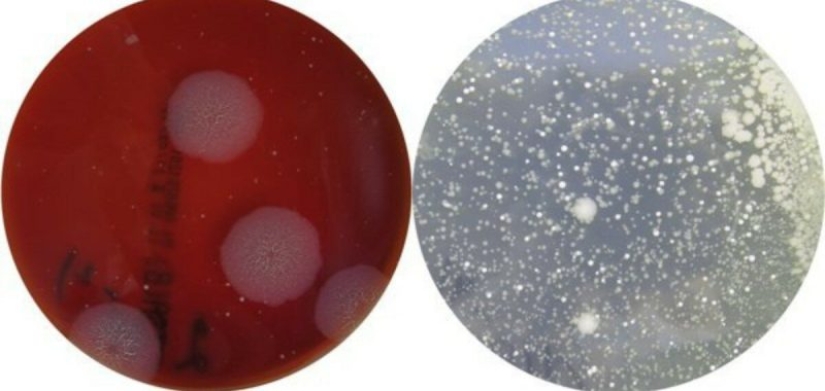
The girl clearly showed the bacterial danger of church icons

The girl clearly showed the bacterial danger of church icons
Categories: Science
By Pictolic https://www.pictolic.com/article/the-girl-clearly-showed-the-bacterial-danger-of-church-icons.htmlDaria Fedorova is a believer and, as is customary among the Orthodox, touches icons in churches. But, as a modern person, the girl wanted to know exactly what lives on the surface of the shrines. She made ten flushes from images in six Moscow churches and conducted a bacteriological analysis of these samples.

It must be said right away that Daria did not set out to make a discovery in microbiology. The girl is studying at the British School of Design and this is just part of her big work called "The Journey of the Human Biome". She wanted to consider icons not as religious objects, but as a home for many different microorganisms.
Fedorova's long-standing project has gained a second meaning recently, against the background of recent events with the coronavirus epidemic. During Orthodox rites, believers come into direct contact with objects that many other people have touched before. Microorganisms living on icons can pose a deadly danger to parishioners, despite their belief in divine protection.
Daria, together with an employee of the biological laboratory, visited temples and made flushes from icons. She did not ask permission from the priests and did not inform the guards, but did it unnoticed, secretly. Fedorova did not even doubt that there would be a lot of interesting things on the images, because on the glass of one of the shrines, traces of lip gloss were visible even to the naked eye.

What is not on the Moscow Orthodox icons
In the old days, when epidemics began, churches were closed, because people guessed that icons could be carriers of infections back in the The Middle Ages. In addition to sacred objects, church wine can also contain dangerous bacteria.

Bacteria from icons look beautiful and intimidating
At communion, when there are 20-30 people in the queue, those who are at the end of the queue no longer drink cahors, but the saliva of previous believers. At the end, you need to kiss the father's hand, with which Daria would also not mind taking an analysis.
Daria and her companion made flushes in six temples located in Zamoskvorechye. The icons of St. Sergius, the Resurrection of Christ, Seraphim of Sarov, St. Elizabeth, the Mother of God, the Baptism of the Lord, Spyridon of Trimifunt, the "Inexhaustible Chalice" were examined.
It turned out that staphylococci, Streptococci, Pseudomonas aeruginosa and E. coli perfectly coexist on the glasses and the salaries of icons. There were also bacteria suspiciously similar to anthrax. Fortunately, it turned out to be only related, non-dangerous microorganisms.Fortunately, all the bacteria from the icons were unpleasant, but not deadly. Despite this, Daria still recommends that before kissing the icon, carefully wipe the glass with a disinfecting cloth. Unfortunately, many believers, and not only Christians, believe that faith is stronger than viruses. For example, this man from Iran, licking the fence of a Shiite mosque, is sure of his safety.
Keywords: Bacteria | Disease | Icon | Moscow | Danger | Orthodoxy | Church
Post News ArticleRecent articles
It's high time to admit that this whole hipster idea has gone too far. The concept has become so popular that even restaurants have ...
There is a perception that people only use 10% of their brain potential. But the heroes of our review, apparently, found a way to ...
Related articles
"Wash your hands before eating!" — a phrase familiar to us since childhood. The parents explained that with the help of this ...
According to the who, from diseases related to Smoking, every eight seconds a person dies. The number of deaths per year up to five ...
We all know that allergies can be cats, dogs, chocolate, citrus fruits and pollen. But things that can cause a dangerous reaction, ...

New Year's is a time to surprise and delight loved ones not only with gifts but also with a unique presentation of the holiday ...